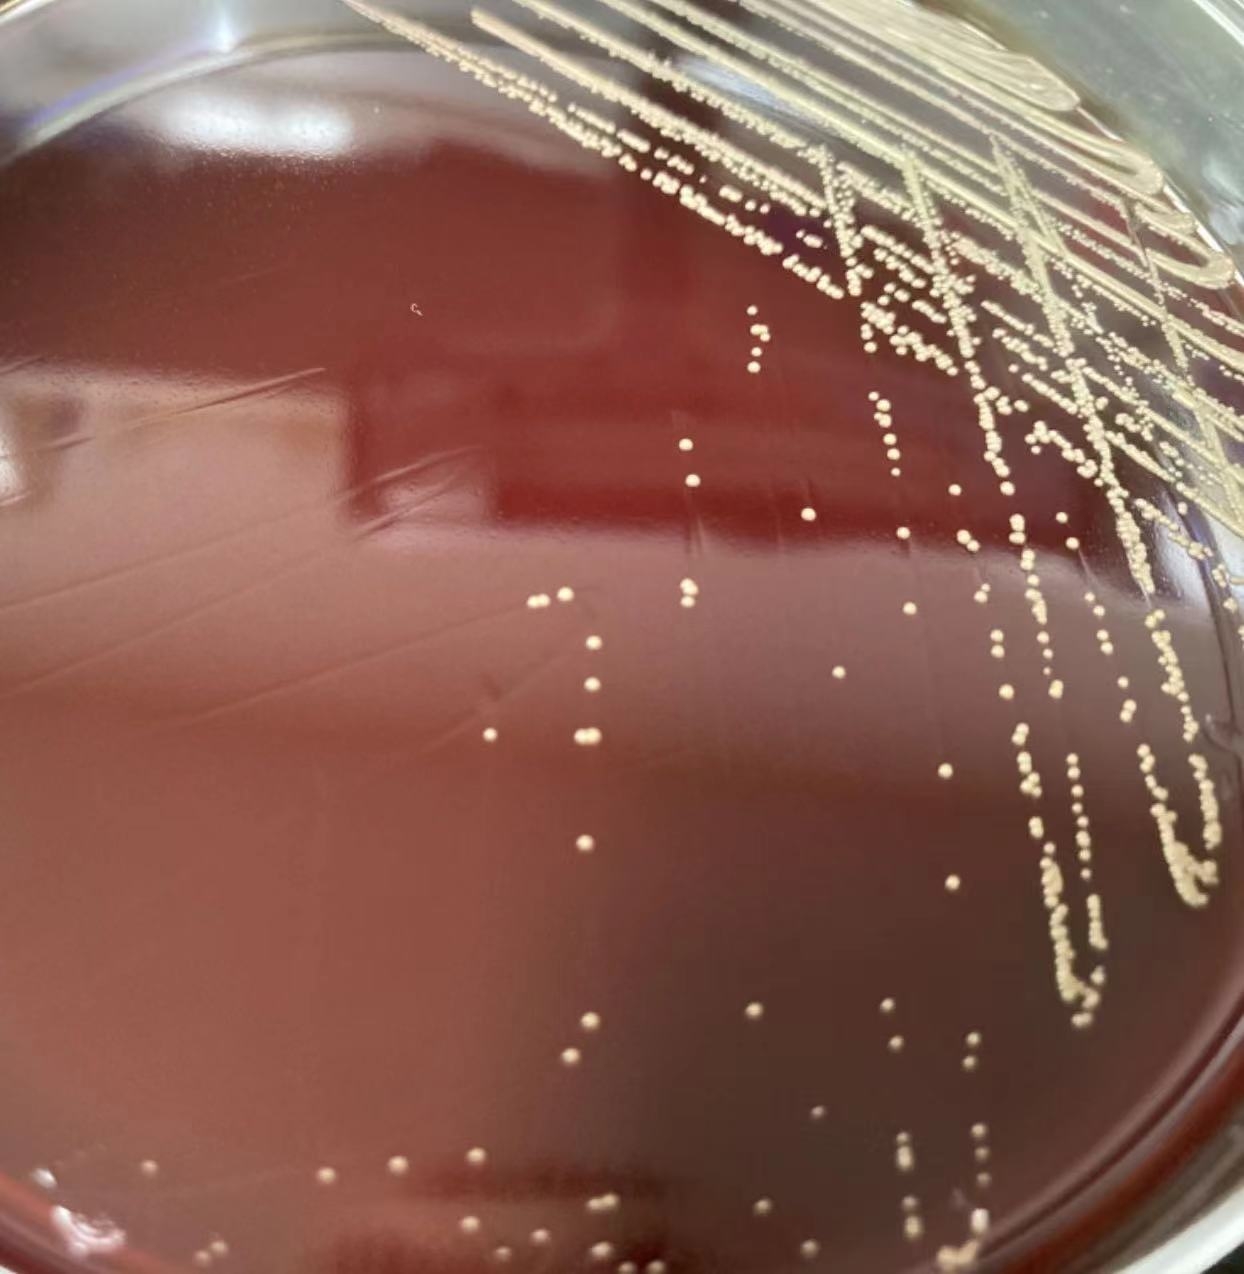
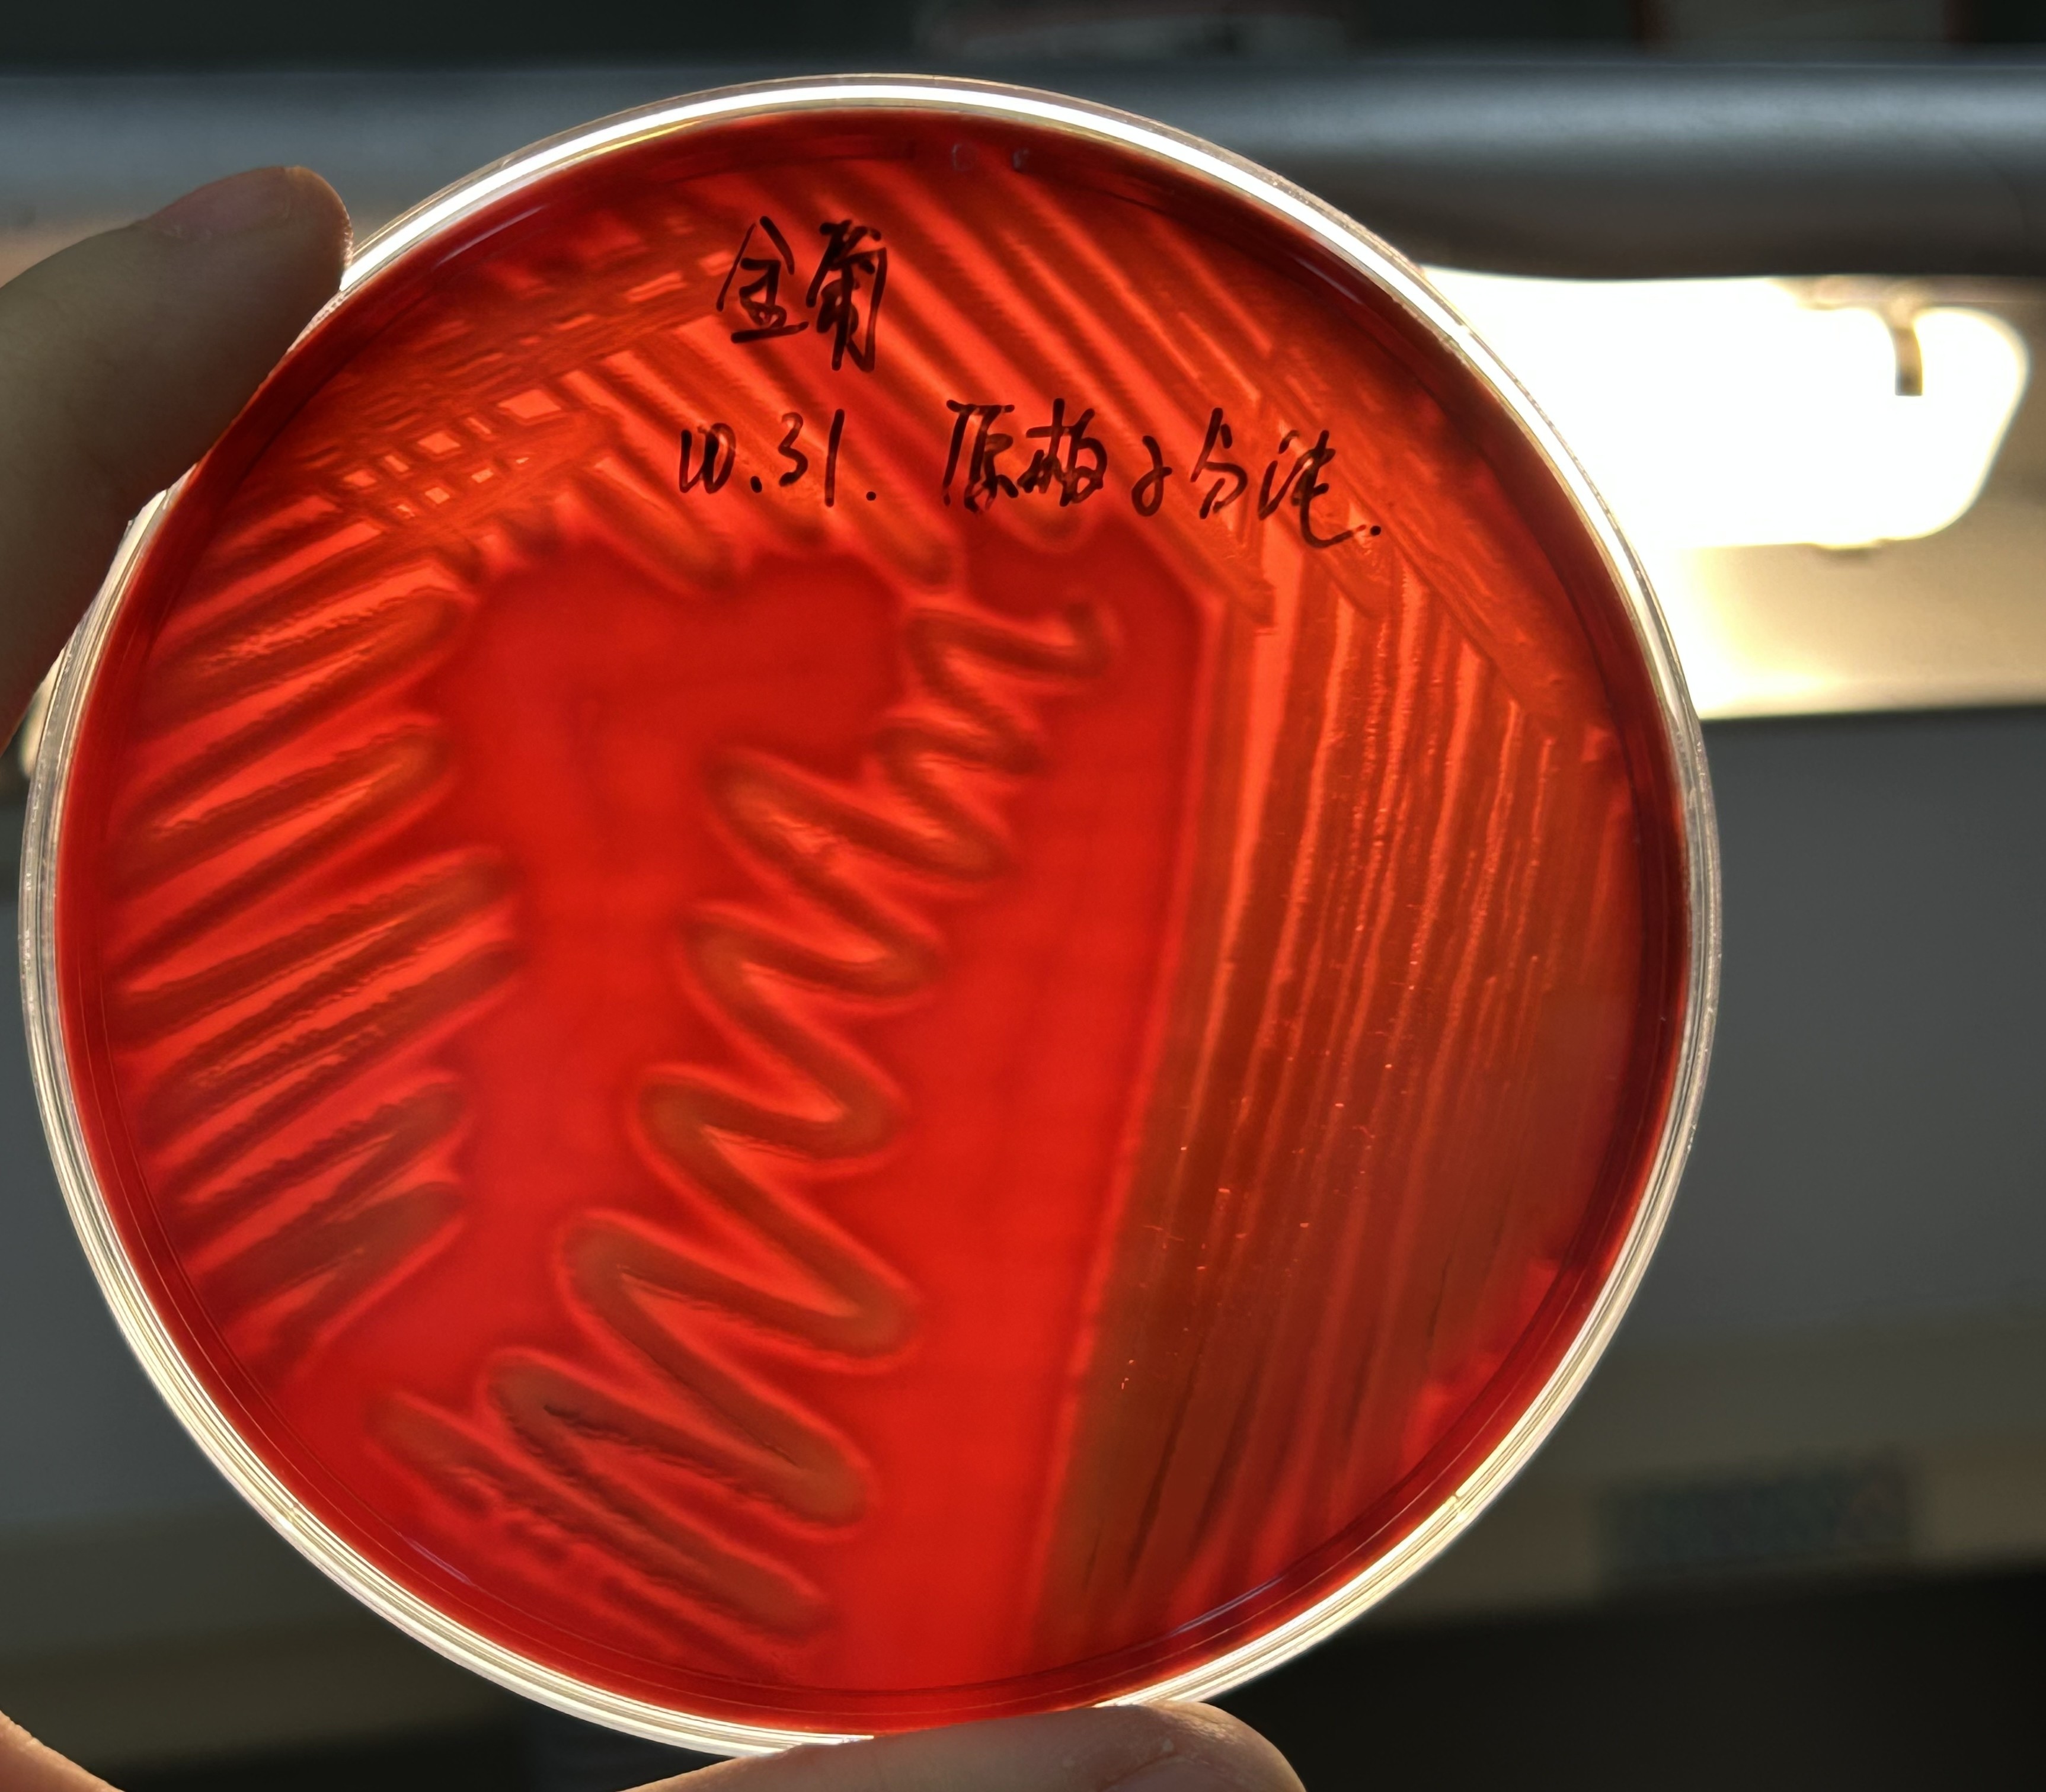
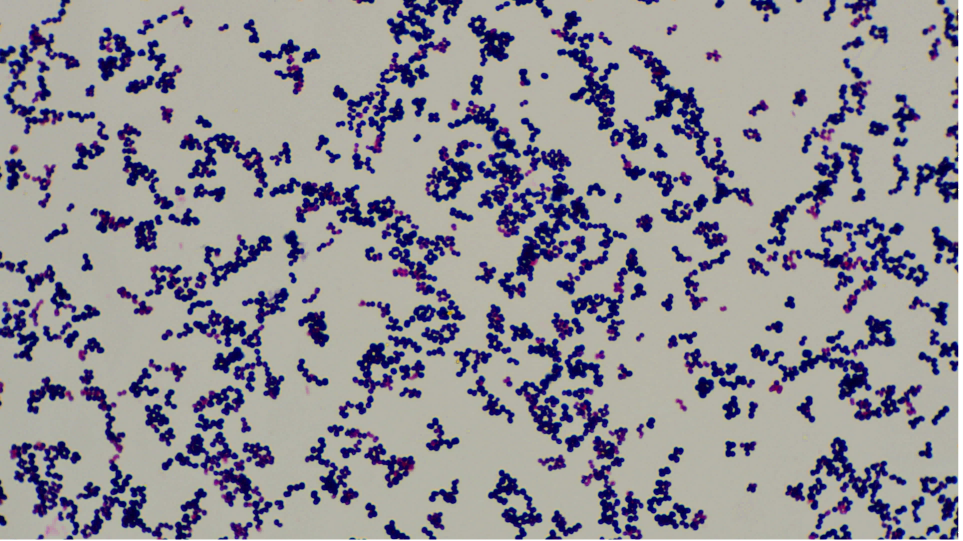

微球菌属-里拉微球菌的鉴别
发布时间:2024-08-28 浏览次数:2479
微球菌属(Micrococcus)在自然环境和人体皮肤及呼吸道中广泛存在,常见于土壤和淡水。虽然微球菌属主要作为非致病病菌,但当人体抵抗力降低时,它们可能通过内源性或外源性途径感染人体,引起关节炎、脑膜炎、肺炎及败血症等各种感染性疾病;对于抵抗力低下的幼儿,微球菌属也可能引起感染,在临床标本中也经常被分离到。里拉微球菌(Micrococcus lylae)为革兰染色阳性球菌,触酶常阳性,菌落形态等与葡萄球菌相似,需进行鉴别。
本文分享一株从二次供水样本中分离出的里拉微球菌的鉴别过程,对某份二次供水样本进行细菌总数、总大肠菌群的常规检测后发现该细菌总数严重超标(多为细小菌落),总大肠菌群检测合格。后利用过滤系统对水样进行过滤、增菌、分离培养(选择血平板、营养琼脂、EMA、BS、SS、MAC、TCBS等培养基,37℃,48h培养),在进行菌种分离培养同时,选取金黄色葡萄球菌标准菌种ATCC 25923为实验对照,进行菌株鉴定。发现血平板上优势菌落为淡黄色,带狭小溶血环;各类选择培养基上则基本无菌落生长,标准菌株ATCC 25923在血平板上呈白色圆形菌落,周围有明显β溶血环,见图1。
![]() | ![]() |
| 里拉微球菌 | 金黄色葡萄球菌ATCC25923 |
| 图1(右键新标签页打开查看高清大图) | |
在血平板上挑取带溶血环的单个小菌落革兰染色后镜检为革兰阳性球菌,呈单个、成对或葡萄串状排列,与葡萄球菌相似见图2。
![]() | ![]() |
| 里拉微球菌 | 金黄色葡萄球菌ATCC25923 |
| 图2(右键新标签页打开查看高清大图) | |
手工生化反应结果:触媒(+)、氧化酶(+)、凝固酶(-)。分离提取的微生物经BD全自动细菌鉴定系统进行生化反应和菌种鉴定,革兰阳性菌鉴定卡的生化反应试验鉴别结果见图3。
里拉微球菌生化鉴定结果
| 金黄色葡萄球菌ATCC25923生化鉴定结果
|
| 图3(右键新标签页打开查看高清大图) | |
总之,里拉微球菌是一种广泛存在于自然环境中的细菌,由于其广泛的分布和潜在的生物活性,里拉微球菌在科研、教学及微生物检测质量控制等领域具有重要的应用价值。同时,里拉微球菌,在特定条件下也可能引发感染。因此,了解微球菌的特性和鉴别方法对于预防和控制相关感染具有重要意义。
作者:罗亚莉
兰州市城关区疾病预防控制中心